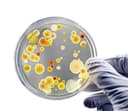
Thumbnail 6

We remain fully operational. Our teams are working around the clock to ensure your deliveries continue safely.

BACKGROUND INFORMATION: LB stands for Luria Broth, a nutritionally rich medium, which is one of the most common media used in the laboratories worldwide. LB medium is recommended safe for student use, whereas Tryptic Soy Agar medium is NOT suitable for student use due to its ability to amplify bloodborne pathogenic bacteria. KIT CONTENT: 1) 10x Pre-poured sterile LB-agar plates (100 x 15 mm Petri Dish) 2) 10x 6-inch sterile cotton swabs (2 per pouch)3) 1x 0.5 oz hand sanitizer 4) 2 x sterile dilution tubes.5) 2 x transfer pipets6) Detailed Instruction7) Free Science Fair Project E-BookLB agar plates should be placed in a refrigerator upon arrival. LB-agar plates stored under such conditions have a minimum shelf life of 3 months. BRIEF INSTRUCTION: 1) Take out one sterile cotton swab. Gently wipe a test area with the cotton swab to pick up bacteria. Here are some of the popular samples of the test objects: human or pet teeth, hands, phone, TV remote, restaurant menu, sink, floor, fruit, vegetable etc. 2) Take out one of the agar plates (No warm-up is needed). Open the agar plate and gently streak the agar plate with the cotton swab to transfer the bacteria onto the surface of the agar plate. 3) Cover the agar plate and place it in an upside-down position in an incubator with a temperature between 85 and 100 oF. A desk lamp or a portable heater can be used as a heat source. 4) Watch appearance of small bacterial colonies on the surface of the agar plates after 12-48 hr of incubation. LIVE TECHNICAL SUPPORT: EZ Prepoured LB agar plates are backed by our 100% money back guarantee. If more technical assistance is needed, we not only provide you with an email address but also a telephone number to talk to our friendly laboratory tech support.
TrustPilot
2 周前
2 周前